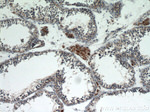
Lin28B Antibody in Immunohistochemistry (Paraffin) (IHC (P))

Search
Proteintech
Lin28B Polyclonal Antibody
{{$productOrderCtrl.translations['antibody.pdp.commerceCard.promotion.promotions']}}
{{$productOrderCtrl.translations['antibody.pdp.commerceCard.promotion.viewpromo']}}
{{$productOrderCtrl.translations['antibody.pdp.commerceCard.promotion.promocode']}}: {{promo.promoCode}} {{promo.promoTitle}} {{promo.promoDescription}}. {{$productOrderCtrl.translations['antibody.pdp.commerceCard.promotion.learnmore']}}
产品信息
16178-1-AP
种属反应
已发表种属
宿主/亚型
分类
类型
抗原
偶联物
形式
浓度
规格
纯化类型
保存液
内含物
保存条件
运输条件
产品详细信息
This antibody is specific to LIN28B.
靶标信息
The GNL1 gene, identified in the human major histocompatibility complex class I region, shows a high degree of similarity with its mouse counterpart. The GNL1 gene is located less than 2 kb centromeric to HLA-E, in the same transcriptional orientation. GNL1 is telomeric to HLA-B and HLA-C.
仅用于科研。不用于诊断过程。未经明确授权不得转售。
生物信息学
蛋白别名: CSD-containing, CCHC zinc finger motif containing; Lin-28.2; Lin-28B; Protein lin-28 homolog B; unnamed protein product
基因别名: CSDD2; LIN28B
UniProt ID: (Human) Q6ZN17
Entrez Gene ID: (Human) 389421